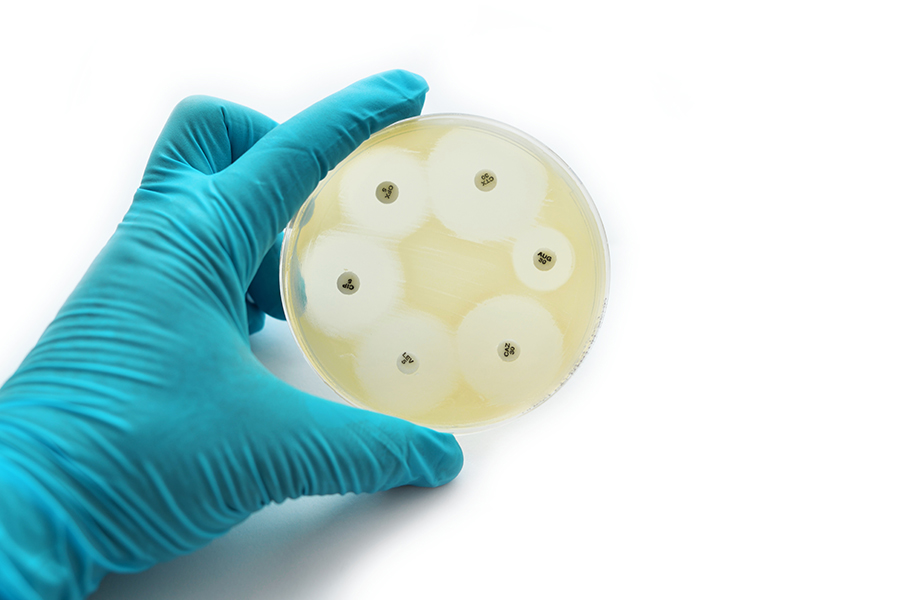

新分子帮助抗菌
多年来过量使用抗生素使其在防治传染性疾病方面效果较差,并导致出现超级bugs抗药性多抗生素万德教授和李文义博士墨尔本大学与协作者一起集中开发新抗菌学来防治超级bugs造成的感染目的是寻找抗生素替代物,通过使用新生化方法有效控制这些感染,包括二元化技术
数十年来滥用抗生素导致全球健康最大威胁之一:抗生素或抗微生物抗药性抗微生物抗药性词描述细菌菌株的出现 即使是最强广度抗生素 也能生存此类感染可能是严重和具有挑战性治疗,并正日益成为全世界残疾和死亡原因
2018年,世界卫生组织(WHO)宣布了一份最危险的抗菌清单,并呼吁紧急开发新抗生素优先级列表中包括aciobacterbaunniigram阴性细菌(表示它不保留Gram染色法作为细菌分治法使用)自那以来,研究人员一直在探索各种方法来消除这种感染,包括新抗生素、疫苗和自然抗菌素,如宿主防毒片

主机防波片
HDP被认为是最古代防疫形式自百年前被发现 自那以来显示杀菌 包括超级虫子 封装病毒 真菌 癌症细胞与抗生素不同,抗微生物小片有强广度特性,很少或没有抗微生物抗药性并可以提高免疫机能的免疫机能(调节免疫机能的模块)
HDP由12-50氨基酸组成向它们提供特征结构 帮助它们消除微生物hDP有正电荷,可与细菌细胞膜和癌症细胞(mbrane活性分子)负电量分子交互HDP和细菌之间的交互作用通常导致薄膜分解、细胞内容泄漏并最终死亡新抗菌药需求比以往更加突出,HDP作用新颖潜在抗生素替代物最近吸引了很多研究者注意。
Proline-rich antimicrobial peptides
富抗菌素是一种HDP类型,高含量氨基酸分线除能穿透细胞膜并调控免疫系统外,它们还可以跨过血脑屏障低毒性和攻击外向和内向细菌的能力使他们有希望选择开发新的抗微生物处理法多重化(生成多分子并发化联结)时,富产HDP显示范围更广的行动并增加反菌性活动基于这一事实,墨尔本大学John Wade教授和Wenyi Li博士决定实验化学修改富集HDP
PROMP稀释
化学程序修改本实验中丰富HDP称为二分法分解过程用单数生成二分数,即分解二分数生成一分数研究者使用专用丰富HDPPROMP单数研究的目的是确定peptides组成crors或它们之间的距离对PrAMP已知反微生物活动有任何作用
7种不同类型的PrAMP硬币组成实验室使用生物相容联系器-特殊分子用来建立单片连接器下一轮测试由抗药性Gram阴性细菌组成板,包括A.巴南尼多药抗药性

挖掘角头的潜力
测试显示六和七型PrAMP插件显示两种菌株的抗菌活动增加A.巴南尼MDR/XDRA.巴南尼.下组测试这两个大有希望PrAMP硬币的杀效率A.巴南尼MDR/XDR细菌富集度不等最高富集度使用 PrAMP 6杀死99%以上A.巴南尼和MDR/XDR细菌60分钟内,而PrAMP7杀>98%A.巴南尼和>99%的MDR/XDR株式
角形分子取向和距离是增加反微生物活动的关键研究者测试两种铅PrAMP的膜渗透性,使用当接触细胞膜(1-N-苯甲胺)时成为荧光的分子测试同两种细菌时,两个大有希望角都显示薄膜渗透与杀菌活动有很强的关联性角头与细菌膜绑定并吸收的能力也使用分子模拟法进行分子级测试。与单片比较结果优待praMPs角头

Wade和Li及其同事还测量响应PrAMP硬币处理后活性氧种的生产ROS已知会造成损害和细胞死亡, 使ROS成为反对有害细菌的有用武器团队结果显示PrAMPs6和7都显著提高ROS生成量,最终导致两种菌株更多细菌死亡
渗透细菌粘液
科学家测试两个大有前途的 PraMP系统干扰细菌生物膜的能力生物胶片是一个厚层细菌组成聚居自产外细胞矩阵(slime),这种构造保护它们不受不良环境因素的影响,例如我们身体的免疫响应praMP成功有效销毁细菌生物膜
最后但并非最不重要的是,使用细胞文化团队设法显示PrAMP硬币增加免疫聚合性能,因为它们诱导免疫保护分子一氧化二氮分解

抗菌感染
Wade和Li的工作证明Cornicpitides6和7展示了对WHO关键优先列表多药抗药性(MDR/XDR)采取强力行动A.巴南尼和生物膜实验显示 角形分子取向 和介质所定义的距离 与单片相比 都关乎抗菌活动增加新化学生物学方法如二分法极有可能开发pitides,这些pepti
个人响应
如何设计研究测试这些新合成硬币 和它们在人体组织中的动作该工作组目前正在研究高效合成法稀疏准备并测试 A.巴南尼受感染鼠标预科模型

